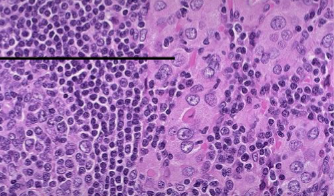
term image

1/63
Looks like no tags are added yet.
Name | Mastery | Learn | Test | Matching | Spaced | Call with Kai |
|---|
No analytics yet
Send a link to your students to track their progress
Thyroid Ectopic Gland
Thyroid gland develops from outpouching of pharyngeal epithelium at base of tongue (Foramen Cecum) which descends along midline forming the temporary Thyroglossal duct
Ectopic thyroid at base of the tongue (Lingual Thyroid) & midline anterior neck (Thyroglossal Duct Cyst)
Hypothalamic-Pituitary-Thyroid Axis
Hypothalamus releases Thyrotropin-Releasing Hormone (TRH) → release of Anterior Pituitary Thyroid-Stimulating Hormone (TSH) → TSH binds TSH receptor on Thyrocytes ↑ Synthesis + ↑ Release of Thyroid Hormones (T4 & T3) → Negative feedback by T3 & T4 to Pituitary Thyrotrophs that ↓ TSH & to the Hypothalamus that ↓TRH
Thyroid Hormone Synthesis and Transport
Thyroid Peroxidase
Thyroid-Binding Globulin/Thyroxine-Binding Globulin (TBG)
free hormone is the biologically active form of the hormone
T3 has most biologic activity
Most of the plasma T3 is derived by peripheral conversion of T4 by tissue Deiodinase
Effects of thyroid hormone
↑ Metabolic rate
↑ thermogenesis
↑ β-Sympathetic activity
Lab tests
primary screening test for thyroid dysfunction is serum TSH
High TSH: Hypothyroidism, follow with a Free T4
Low TSH: Hyperthyroidism, follow with a Free T4 + Total T3
Estrogens → ↑ Total T4 & T3 because Estrogens ↑ carrier proteins
Biotin → ↓ TSH & ↑ T3 & T4
Drugs, Glucocorticoids, Dopamine also ↓ TSH
Hyperthyroidism
Thyrotoxicosis: Hypermetabolic state caused by ↑ Free T3 & T4
Hyperthyroidism: ↑ T3, T4
Primary hyperthyroidism: Pathology in the thyroid tissue
Secondary Hyperthyroidism: pathology not of the thyroid gland itself
2 mechanisms → 24-hour radioiodine uptake scan:
↑ de novo hormone synthesis in thyroid gland: Normal or high radioiodine uptake
↑ release of pre-formed hormone (without synthesis) or extra-thyroidal source: Near absent radioiodine uptake
Thyrotoxicosis
Tachycardia, Arrhythmias (palpitations)
Exophthalmos
Graves → Pretibial myxedema
More common in older people:
Apathetic type (symptoms blunted)
Depression
CHF, Cardiomegaly
Irregular heartbeat (A-Fib common)
unexplained weight loss
Graves Disease
Hyperthyroidism with diffuse thyroid gland enlargement
Infiltrative Ophthalmopathy → Exophthalmos
Localized infiltrative dermopathy (Pretibial Myxedema)
Autoimmune disorder with anti-thyroid antibodies to the TSH Receptor
Binding of autoantibodies to the TSH receptor → stimulate TSH receptor (Thyroid-stimulating Immunoglobulin / TSI)
Female , peak incidence 30-40 years
Graves Disease: Exophthalmos/Proptosis/Graves Orbitopathy
Fibroblasts in retro-orbital space (& some dermal fibroblasts) have TSH Receptors & IGF-1 Receptors
TSH Receptor Antibodies (TSI) bind & stimulate fibroblasts to proliferate & differentiate into myofibroblasts & secrete Hyaluronic acid
↑ volume of the retro-orbital tissues & extraocular muscles → eyes to progressively bulge out (Exophthalmos), diplopia, blurred vision, light sensitivity
Fibroblasts in dermis of shins → Infiltrative Dermopathy (Pretibial Myxedema)
Skin Changes of Graves Disease
Infiltrative Dermopathy (formerly: Pretibial Myxedema)
skin over shins scaly, orange peel-like thickening
pigmented papules or nodules
Acropachy: clubbed fingers & swollen hands → Associated with Ophthalmopathy

Infiltrative Dermopathy

Infiltrative Dermopathy

Acropachy

Infiltrative Dermopathy

Infiltrative Dermopathy
Skin: separation of collagen fibers by mucin in reticular dermis
Neonatal Thyrotoxicosis
if Mom has Graves Disease
→ TSI crosses placenta (are IgG)
→ Maternal thyroid hormones cross placenta
Thyroid Storm
Severe clinical manifestations of Thyrotoxicosis:
Tachycardia > 140 or Heart Failure
Fever (104-106 °F)
Altered mentation (Agitation, anxiety, delirium, psychosis, stupor, or coma)
Labs: ↓ TSH and ↑ free T4 and/or total T3
Precipitated by acute ↑ in catecholamines from a medical event or other stressor

Graves Disease
diffusely enlarged, hyperplastic gland
bruit from increased arterial blood flow
may cause difficulty in swallowing
Gland smooth & soft; capsule smooth

Graves Disease
Dilated follicles lined by increased numbers of tall follicular cells with papillary infoldings
Scalloped colloid (↑ pinocytosis of colloid)
Granulomatous (De Quervain) Thyroiditis
Females predominate; peaks age 30-50
Pathogenesis: Triggered by Viral infection; “Viral thyroiditis”; usually after URI; peaks in the summer
tissue damage from activation of cross-reactive cytotoxic T-cells by virus
Thyroid is Painful or tender; worse on swallowing; radiates to jaw, ears
Constitutional symptoms often absent
Transient Thyrotoxicosis, followed by transient hypothyroidism with complete symptomatic & metabolic recovery in ≈2 months (Self-limited)
Radioactive nuclide uptake is not increased
Sometimes called "Subacute Painful Thyroiditis"

Granulomatous (De Quervain) Thyroiditis
Gland enlarged; firm
Most common cause of thyroid pain
Histology: Multinucleated giant cells = Granulomatous
Chronic inflammation with multinucleated Giant Cells surrounding pools of colloid
Hypothyroidism Types
Primary: Thyroid gland problem; majority; Labs ↑ TSH, ↓ Free T4
Secondary: Pituitary destruction/insufficiency; Labs: ↓ TSH; ↓ Free T4
Tertiary: Hypothalamic: ↓ TRH, ↓ TSH, ↓ Free T4
Hypothyroidism in the Fetus & Infant
Maternal thyroid hormones cross the placenta
Maternal deficiency in early pregnancy affects fetus most, impairing brain development
Fetal Hypothyroidism (Congenital Hypothyroidism): maternal thyroid hormones protects the fetus until birth; born relatively normal
Maternal + Fetal Hypothyroidism (Congenital Iodine Deficiency/Cretinism)
Cretinism
Weak muscle tone (Floppy baby); puffy face
Coarse facial features & hair
Large, protruding tongue
Protruding abdomen, Umbilical hernia
Hoarse cry
Constipation
Cool, pale skin
Slow skeletal growth, short stature
Impaired CNS development
Myxedema
Hypothyroidism in older children/adult
Puffiness of face, eyelids, hands (“non-pitting edema”) due to accumulation of extracellular matrix (ECM) substances
Hypothyroidism
Cold intolerance
Weight gain
Slow pulse (Bradycardia)
puffy face, hands, feet (Generalized Myxedema)
Hair loss; brittle fingernails
Constipation
Carpal tunnel syndrome
More common in older people:
High cholesterol
Heart failure
Bowel movement changes, usually constipation
Joint pain or general muscular pain
Depression or psychosis
Dementia
Unsteadiness while walking
Chronic Lymphocytic Thyroiditis (Hashimoto Thyroiditis)
Autoimmune thyroiditis with progressive gland destruction & eventual Hypothyroidism
Women
peak incidence 45-65 years
Caused by breakdown in self-tolerance to thyroid autoantigens
Infiltrates of Lymphocytic cells, progressive depletion of Thyrocytes, intra-glandular fibrosis
Chronic Lymphocytic Thyroiditis (Hashimoto Thyroiditis) Clinical
Painless symmetric diffuse thyroid enlargement (eventual fibrosis may shrink)
Hypothyroidism
Increased risk for B-cell MALT lymphoma
Screen with TSH + Free T4 (↑ TSH, ↓ Free T4)
Anti-Thyroid Peroxidase antibody (anti-TPO)
Anti-Thyroglobulin antibody (anti-TG)
TSH receptor blocking immunoglobin
Thyroid Moderately enlarged thyroid
Rubbery, nodular fleshy cut surface

Chronic Lymphocytic Thyroiditis (Hashimoto Thyroiditis)

Chronic Lymphocytic Thyroiditis (Hashimoto Thyroiditis)

Chronic Lymphocytic Thyroiditis (Hashimoto Thyroiditis)
Infiltrate of Lymphocytes with germinal centers (Struma Lymphomatosa)
Chronic Lymphocytic Thyroiditis (Hashimoto Thyroiditis)
Hurthle cells

Chronic Lymphocytic Thyroiditis (Hashimoto Thyroiditis)
Subacute Lymphocytic (painless) Thyroiditis
Autoimmune (anti-TPO & anti-TG Ab)
3 phases: Initial Transient Hyperthyroidism, later as Transient Hypothyroidism, then recovery
mild transient Hyperthyroidism +/- thyroid enlargement with ↓ RAIU & negative TSI
Sporadic form usually seen in middle aged women; Post Partum form is most common
Morphology: Lymphoid infiltration with germinal centers, but fewer Hurthle cells
about 1/3 become permanently hypothyroid with Chronic Lymphocytic Thyroiditis (Hashimoto)
Reidel Thyroiditis (Reidel struma)
middle aged Adults
firm (“rock hard”), fixed, painless enlargement (mass) due to chronic inflammation with dense fibrosis of the thyroid & contiguous neck structures
Micro: collagenized tissue with lymphs, plasma cells & eosinophils within & outside of thyroid capsule
Hypothyroidism, tracheal compression, & recurrent laryngeal nerve impingement (vocal cord paralysis)
Manifestation of IgG4-related disease; associated with fibrosis of retroperitoneum, salivary glands, mediastinum, pancreas
Goiter
Impaired synthesis of thyroid hormone due to Iodine deficiency or enzyme defect → compensatory ↑ TSH
TSH causes ↑ in thyroid mass (hyperplasia) & usually maintains Euthyroid state (but if unable to compensate → hypothyroidism)
Enlargement is proportional to level & duration of hormone deficiency
Multinodular goiter develops in most longstanding simple goiters due to recurrent episodes of hyperplasia & involution
Hyperplasia gives opportunity for clonal nodules to arise
Low iodine in soil/food
Goitrogens
Multinodular goiter
Mass effects - compress neck structures, thoracic vessels
Intrathoracic extension = plunging goiter
Airway obstruction; deviation of trachea
Development of Clonal nodules:
With activating mutations in TSH receptor gene → Clonal, Autonomous Hyperfunctioning nodules may cause Thyrotoxicosis (Toxic Multinodular Goiter, aka, Plummer Disease)
Risk of Follicular Carcinoma is low
Nodular, asymmetrically enlarged
Regressive changes: hemorrhage, fibrosis, calcification, cysts

Multinodular goiter
Euthyroid Sick Syndrome (Nonthyroidal illness syndrome)
Laboratory changes in thyroid function tests in patients in the medical ICU, starvation (anorexia nervosa) or with other critical illness
Clinically Euthyroid
Thyroid function should not be assessed in seriously ill patients unless there is a strong suspicion of dysfunction
↓ total & free T3
reverse T3 (rT3) is increased
Follicular Adenoma
Most common neoplasm of thyroid
follicular epithelium derived
NOT precursor of carcinomas
Solitary, well circumscribed, painless
Vast majority are non-functioning & Cold on Scan
A few are functional & hot on scan (“Toxic Adenomas”)
Histology: Uniformly sized follicles with colloid (microfollicles); Hurthle/oxyphil cell change
Hallmark is the presence of an intact collagenous capsule encircling the tumor
Follicular Carcinoma
Capsular invasion and/or vascular invasion

Follicular Adenoma
circumscription, collagenous capsule, & central hemorrhage/cystic change

Follicular Adenoma
circumscription, collagenous capsule

Follicular Adenoma
circumscription, collagenous capsule



Follicular Adenoma
Larger follicles, thinner capsule

Follicular Adenoma
Hurthle Cell
Papillary Thyroid Carcinoma (PTC)
RET or Translocation (fusion gene)
BRAF V600E
Risk factors: Ionizing radiation, Female
Gross: solitary or multifocal; Microcarcinoma
Micro: Papillae with fibrovascular stalks; neoplastic epithelium covering stalks shows variable atypia
Nuclei: Optically clear or ground glass nuclei; nuclear pseudo-inclusions, grooves
Concentric calcifications (Psammoma bodies)
Behavior: early spread via Lymphatics; metastases to cervical nodes; neck node mass frequent; Excellent px
Follicular Thyroid Carcinoma (FTC)
RAS
Familial: Loss of PTEN (Cowden)
Peak age 40-60; more common in women
Risk: Iodine deficient areas
circumscribed or grossly infiltrative
Micro: most Microfollicles with intraluminal colloid
some show abundant eosinophilic cytoplasm (Oncocytic/Hurthle cell variant)
Behavior: most often a cold nodule; Hematogenous spread preferentially (mets to bone, lungs, liver)
Good px
Medullary Thyroid Carcinoma (MTC)
RET receptor GOF mutation
In germline defines Familial MEN-2
Neuroendocrine neoplasm derived from the parafollicular Calcitonin secreting cells (C-cells)
Gross: In MEN-2, younger, Bilateral/Multicentric; sporadic single nodule
Lack capsules (are infiltrative)
Micro: Neoplastic cells in nests/ribbons with background deposition of Amyloid (derived from Calcitonin)
EM: Neurosecretory granules
Associated C-cell hyperplasia
Mass; destructive infiltration or pressure locally (hoarseness, dysphagia)
Paraneoplastic syndrome (diarrhea due to VIP, Cushing due to ACTH)
Raised serum Calcitonin & CEA
Anaplastic Thyroid Carcinoma
Highly aggressive thyroid carcinoma of undifferentiated follicular cells
evidence of epithelial differentiation but are devoid of morphologic & immunophenotypic markers of thyroid origin
most succumb within a year
Risk factors: Older age, Goiter (chronic Iodine deficiency), past thyroid cancer
Rapidly enlarging (days/weeks), bulky, fixed neck mass
Hoarseness, dyspnea, dysphagia as neck compressive symptoms
Extrathyroidal extension
Regional nodal metastases & vocal cord paralysis
Majority have distant metastases
spindle cell sarcoma-like appearance
Most + PAX8 (Nuclear marker for epithelial neoplasms), +/- Cytokeratin

Follicular Thyroid Carcinoma
Capsular invasion in Minimally Invasive FTC

Follicular Thyroid Carcinoma
FTC involving most of a lobe

Follicular Thyroid Carcinoma
abortive microfollicles making recognizable colloid

Papillary Thyroid Carcinoma
Papillary folds

Papillary Thyroid Carcinoma
Papillary folds
Psammoma Body

Papillary Thyroid Carcinoma

Papillary Thyroid Carcinoma
Gross specimen with papillae

Medullary Thyroid Carcinoma

Medullary Thyroid Carcinoma
Congo Red stain For Amyloid

Medullary Thyroid Carcinoma
Endocrine neurosecretory granules

Medullary Thyroid Carcinoma

Medullary Thyroid Carcinoma

Anaplastic Thyroid Carcinoma